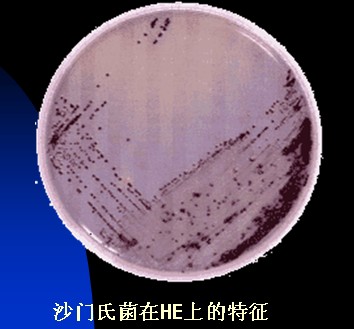
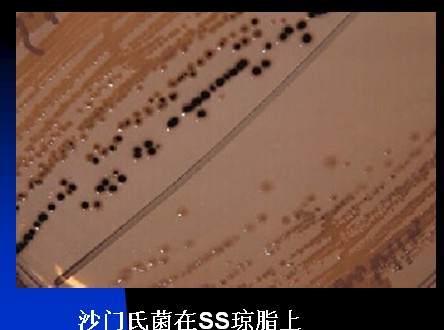

海博微信公众号
海博微信公众号
 海博天猫旗舰店
海博天猫旗舰店


 海博微信公众号
海博微信公众号
 海博天猫旗舰店
海博天猫旗舰店




|
琼脂平板
|
菌 落 特 征
|
|
|
沙 门 氏 菌
|
亚 利 桑 那 菌
|
|
|
亚硫酸琼脂
|
棕褐色或灰色至黑色,有时有金属光泽,周围培养基呈棕色或黑色,有些菌株呈灰绿色,周围培养基不变或微变暗
|
黑色,周围培养基一般不变黑或微变黑。有些菌株呈灰绿色,带黑心或不带黑心
|
|
胆硫乳琼脂
|
无色半透明有黑色中心或几乎全为黑色。有些菌株无色半透明
|
乳糖阴性菌株,相似于沙门氏菌菌落,乳糖阳性菌株为粉红色有暗色中心
|
|
亚利桑那菌琼脂
|
黄色有暗蓝色中心,周围培养基中有黄色沉淀物
|
粉红色有黑色中心,有时为全黑色周围培养基呈红色,被发酵卫矛醇或庶糖的细菌包围时,菌落边缘可为浅黄色
|

上一篇:非选择性培养基



